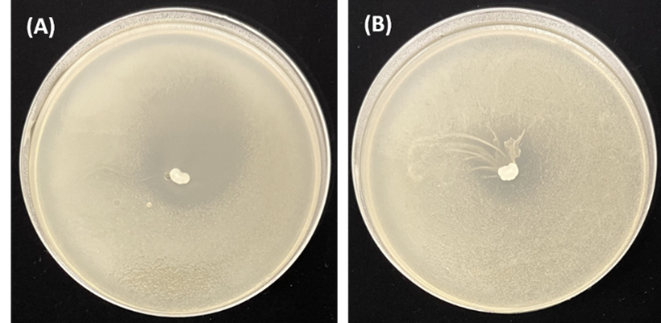

Trends
Sci.
2026; 23(1): 11456
Enhanced Nutritional and Bioactive Properties of Riceberry Rice Amazake Lactic Fermented with Thermotolerant Pediococcus acidilactici FSPO-PJ1
Sirinan Shompoosang1,*, Junichiro Marui2, Safiah Saah1,
Thoranin Intarajak3 and Patthinan Varichanan1
1Institute of Food Research and Product Development, Kasetsart University, Bangkok 10900, Thailand
2Japan International Research Center for Agricultural Sciences (JIRCAS), Ibaraki 305-8686, Japan
3Bureau for Research and Innovation Management, HRH Princess Chulabhorn College of Medical Science Chulabhorn Royal Academy, Bangkok 10210, Thailand
(*Corresponding author’s e-mail: [email protected])
Received: 1 August 2025, Revised: 26 August 2025, Accepted: 5 September, Published: 20 October 2025
Abstract
Thailand is rich in microbial and crop biodiversity, making it ideal for functional food development. This study used Pediococcus acidilactici FSPO-PJ1, a thermotolerant lactic acid bacteria (LAB) strain isolated from Thai fermented food, to ferment Thai riceberry rice amazake lactic, a functional beverage made from Thai pigmented rice. This strain, isolated from fermented spring onion, was selected for its thermotolerance and evaluated for antagonism against foodborne pathogens (Bacillus cereus and Staphylococcus aureus) to verify its food safety profile. Enhancements of the health-related functional properties of riceberry rice amazake fermented with P. acidilactici FSPO-PJ1, such as nutrition, metabolites and bioactivities, were assessed and compared with those of conventional riceberry rice amazake (RB-AMA). Parallel fermentation of riceberry rice amazake lactic with rice koji and P. acidilactici FSPO-PJ1 at 50 C (FSPO-PJ1 amazake) yielded significantly higher concentrations of lactic acid, amino acids (histidine, lysine, cysteine, glycine, proline, alanine, leucine and methionine) and vitamin B (B1, B2, B3 and B9) than RB-AMA. FSPO-PJ1 amazake also had significantly higher concentrations of total phenolic compounds (1.274 vs. 1.080 mg GAE/g) and significantly higher antioxidant activity than RB-AMA (0.278 vs. 0.052 mg TE/g). Moreover, FSPO-PJ1 amazake demonstrated anti-inflammatory activity by inhibiting nitric oxide (NO) in lipopolysaccharide-stimulated RAW 264.7 cells; FSPO-PJ1 amazake treatment exhibited significantly higher NO inhibition (46.07%) than treatment with RB-AMA (40.86%) or the NO synthesis inhibitor NG-nitro-l-arginine methyl ester (L-NAME; 40.92%). This study is the first to demonstrate the potential of newly isolated P. acidilactici FSPO-PJ1 in enhancing nutritional and bioactive properties in riceberry rice amazake lactic, providing a novel approach for functional fermented food production.
Keywords: Pediococcus acidilactici, Nutrition, Bioactivity, Amazake lactic, Riceberry rice, Fermented food, Functional food
Introduction
Functional foods are designed to offer health benefits beyond basic nutrition when consumed regularly as part of a balanced diet. Fermentation with lactic acid bacteria (LAB) is a widely used strategy for incorporating bioactive constituents into foods to meet the criteria of functional food [1]. LAB are generally recognized as safe and have multiple beneficial metabolites, such as vitamin B, which can maintain the nervous, muscular and immune systems; exopolysaccharides, which are related to immunomodulatory, anti-inflammatory and antioxidant activities; and organic acids or bioactive peptides, which can have antimicrobial properties [1-4]. Among LAB, Pediococcus acidilactici is used as a starter culture in fermented foods, including meat, fish and vegetables. It is a Gram-positive coccus in genus Lactobacillaceae which has optimal growth temperature at 40 C and maximum growth temperature at 50 C [5]. P. acidilactici exhibits probiotic properties; prevents hyperglycemia, hypercholesterolemia and gastrointestinal infection; produces bioactive compounds that resist foodborne pathogens; and enhances antioxidant levels in fermented food products [2,4]. It can also produce amino acids [6] and vitamin B [7,8], thereby enhancing nutritional value.
Amazake is a traditional Japanese, fermented, nonalcoholic drink produced by saccharifying rice with Aspergillus oryzae in rice koji at high temperatures (50 - 60 C). It is nutritious and rich in functional components, including monosaccharides, oligosaccharides, dietary fibers, vitamin B, amino acids, organic acids and active ingredients, such as antioxidants (L-ergothioneine), glucosylceramide (GlcCer), N-acetylglucosamine (GlcNAc) and γ-aminobutyric acid (GABA) [9-11]. Sometimes called a “drinkable IV drip” or a “super drink,” amazake can be consumed by kids, older people and pregnant women because of its readily absorbable small-molecule metabolites. Its documented health functions include antifatigue effect, improved bowel regularity, enhanced skin barrier function, reduced joint pain and increased cholesterol metabolism [9-13]. LAB fermentation can further enhance amazake’s bioactivity; for example, compared with traditional koji amazake, amazake fermented by Lactobacillus sakei UNONUMA exhibited increased lactic acid; vitamins B2, B3 and B6; and acetylcholine levels [11].
Thailand has a wide variety of rice cultivars, including pigmented, high nutrition and health functional rice. Riceberry rice (Oryza sativa L.) is a long-grain, dark purple and nonglutinous variety developed by crossbreeding aromatic black rice (Hom Nin rice) and jasmine rice (Khao Dawk Mali 105) to improve texture, flavor and aroma. This variety is also nutritious, being rich in omega-3, minerals (Zn and Fe), vitamins (E, B1 and B2), -carotene, lutein, polyphenol, tannin, γ-oryzanol, antioxidant and fiber [14]. Riceberry rice is widely consumed in Thailand and also used in making functional food products, such as snacks, beverages and yogurt [14-16].
This study used Pediococcus acidilactici FSPO-PJ1, a thermotolerant LAB strain newly isolated from Thai fermented food, for the development of a novel variety of functional fermented food, riceberry rice amazake lactic. The strain was evaluated for its properties relevant to amazake lactic production including thermotolerance and antagonistic activity against foodborne pathogens. The resulting product’s nutritional and bioactive properties were compared with those of conventional riceberry rice amazake.
Materials and methods
Materials
Fermented food samples were obtained from local markets in Thailand. Rice koji of Aspergillus oryzae was a product of Kojiya Sanzaemon (Aichi, Japan). RAW 264.7 murine macrophages were supplied by the American Type Culture Collection (Manassas, VA, USA). We used a commercial riceberry rice product (PRG Corporation Public, Pathumthani, Thailand). All cell culture products were supplied by Invitrogen (via Gibthai, Bangkok, Thailand). All chemicals were of analytical grade.
Isolation of LAB
LAB were isolated from Thai fermented food containing rice material, including sweet fermented glutinous rice (khao mak), fermented pork or beef (nham) and fermented vegetables. Pure bacterial cultures were screened for catalase activity; catalase-negative strains were further observed by Gram staining. Working cultures were cultivated on de Man-Rogosa-Sharpe (MRS) agar (HiMedia, Mumbai, India) at 37 C for 16 - 24 h. Stock cultures were preserved in sterilized 20% (v/v) glycerol at −80 C.
Thermotolerance screening
Primary thermotolerance screening of isolated LAB strains was conducted by spot-inoculating isolates with a sterilized toothpick on MRS agar, followed by incubation at 45, 50 and 55 C for 24 h. Strains that grew at those temperatures were subjected to secondary screening in riceberry rice amazake using the parallel fermentation method as follows. First, 5 g of raw riceberry rice was soaked overnight in 10 mL of reverse‑osmosis water at 4 °C in a 50-mL glass vial and then boiled at 105 °C for 30 min using an autoclave sterilizer (ES-315; TOMY, Tokyo, Japan). The mixture was inoculated with 3 g of rice koji and a cell suspension of LAB at 106 CFU/g of rice mixture, mixed thoroughly and incubated at 45, 50 and 55 C in a water bath (Thermominder SM-05N; Taitec Corporation, Saitama, Japan) for 16 h. The negative control was amazake mock-inoculated using sterilized water instead of a LAB cell suspension and incubated under the same conditions. Sugar content was measured using a pocket refractometer (PAL-S, Atago, Tokyo, Japan). pH was measured using a pH meter (LAQUAtwin pH-33, Horiba Advanced Techno, Kyoto, Japan). Acidic pH in the LAB-amazake culture medium reflects LAB growth and acid production. Therefore, LAB strains that resulted in a culture pH < 4 were selected. Furthermore, the maximum temperature at which the selected LAB strain could grow and still acidify the LAB-amazake culture was selected as the temperature condition for further amazake lactic production.
Antagonism against foodborne pathogens
The antagonistic activity of the selected LAB strain FSPO-PJ1 against B. cereus TISTR 687 and S. aureus DMST 8840 - foodborne pathogens that may contaminate amazake products - was analyzed using an agar overlay method [17]. FSPO-PJ1 was inoculated with a loop-full (approximately 105 CFU/spot) on MRS agar and incubated at 37 C for 48 h. MRS agar plates with FSPO-PJ1 colonies were overlaid with 10 mL of soft nutrient agar (0.8% agar) premixed with each foodborne pathogen (final number: 106 CFU/mL) and incubated at 37 C for 24 h. The zone diameter of inhibition (ZDI) was interpreted as follows: ZDI > 20, 10 - 20 and < 10 mm were defined as strong, intermediate and weak inhibition, respectively. The width of the clear zone (R) was calculated using Eq. (1) where d Inhib and d Spot are the diameter of the clear zone and diameter of the LAB colony, respectively.

Inhibition capacity was dependent on the R value, with < 2, 2 - 5 and > 6 mm indicating no, low and high inhibition capacity, respectively.
Bacterial identification and phylogenetic tree
FSPO-PJ1 was cultivated in MRS broth at 37 C for 16 h. Genomic DNA was extracted using the Maxwell RSC Tissue DNA Kit (Promega Corporation, Madison, WI, USA), following the manufacturer’s instructions. Genomic DNA libraries were constructed using the TrueSeq Nano DNA Kit (Illumina, San Diego, CA, USA). The quality and quantity of extracted genomic DNA was examined using Nanodrop ND-200 (Thermo Fisher, Waltham, MA, USA) and the integrity was assured on agarose gel electrophoresis. Whole-genome sequencing was conducted following the 151 bp paired-end sequencing protocol of the Illumina platform using an Illumina NovaSeq 6,000 sequencer according to the manufacturer’s instructions (Macrogen, Seoul, Korea) [2].
Raw sequencing reads were assessed for quality using FastQC v0.12.0 [18] and subsequently trimmed using Fastp v0.24.0 [19] and Trimmomatic v0.40 [20]. Genome assembly was performed with SPAdes v4.0.0 using the isolate flag and a memory allocation of 400 MB (–m 400) [21]. LAB strain FSPO-PJ1 was identified at the species level and local sequence alignment was performed using the standalone BLAST tool (blastn) [22]. For phylogenetic analysis, open reading frames, RNA genes and coding DNA sequences were identified and genome annotation was performed using Prokka v1.14.6 [23]. The resulting general feature format files were subsequently used. A phylogenetic tree was constructed based on the presence and absence of core and accessory (pan) genes using Roary v3.13.0 [24] and visualized using the interactive Tree of Life (iTOL) v6 [25]. The reference genome sequences of Pediococcus and the outgroup (Lactiplantibacillus plantarum SRCM100442) were retrieved from GenBank. Accession numbers for reference genomes are as follows: FAM13875: PRJNA576774; TMW 2.1536: PRJNA290141, NBRC 100673: PRJDB6092; LMG 24279: PRJNA1208221; ATCC 25745: PRJNA398; NIBL1955: PRJNA1086194; SRCM100442: PRJNA438180; ATCC 8042: PRJNA503305; DSM 20284: PRJNA50527; and PMC65: PRJNA632644.
Data accession
The complete genome sequence of P. acidilactici FSPO-PJ1 was deposited in GenBank (accession number: PRJNA1263644; release date: January 1, 2026).
Production of riceberry rice amazake lactic
The riceberry rice amazake lactic fermented with LAB strain FSPO-PJ1 was designated FSPO-PJ1 amazake. It was prepared using parallel fermentation per the aforementioned mixture ratio and method. The conventional riceberry rice amazake (designated RB-AMA) was prepared similarly except sterilized distilled water was used instead of the LAB cell suspension. Figure 1 presents schematics for the production of riceberry rice amazake lactic by parallel fermentation and the production of riceberry rice amazake by the conventional method. Following fermentation, both FSPO-PJ1 amazake and RB-AMA were boiled at 100 C for 20 min, homogenized for 1 min in a food processor (Silent Millser; Iwatani, Osaka, Japan) and maintained at −20 C until further use. pH and sugar content were measured as previously described.

Figure 1 Schematic of (A) production of riceberry rice amazake lactic by parallel fermentation and (B) production of riceberry rice amazake by conventional method.
Sugar analysis
The sugars, including glucose, maltose, isomaltose, maltotriose and isomaltotriose, in FSPO-PJ1 amazake and RB-AMA were measured using high-performance liquid chromatography (HPLC). Mono- and disaccharides (glucose, maltose and isomaltose) were quantified using an HPLC system (Shimadzu, Kyoto, Japan) equipped with an Asahipak NH2P-50 4E column (Shodex, Tokyo, Japan). The sample was eluted through isocratic flow with acetonitrile-water (73:27 (v/v)). The trisaccharides (maltotriose and isomaltotriose) were analyzed using an HPLC system (1,260 Infinity II; Agilent, Santa Clara, CA, USA) equipped with a Fortis Amino FNH-050705 column (Fortis, Pasig, Philippines). The sample was eluted through isocratic flow with acetonitrile-water (75:25 (v/v)). Eluted sugar was detected using an RI detector.
Lactate analysis
Lactate was measured using a reflectometer (RQflex 20) with Reflectoquant lactic acid test strips (Merck Millipore, Burlington, MA, USA), according to the manufacturer’s instructions. Each sample was homogenized for 1 min with four volumes of water by Silent Millser (Iwatani, Osaka, Japan). Subsequently, the homogenized sample was mixed with an equal volume of water and stirred at 2,400 rpm for 1 h at 4 °C with a multitube vortexer BSR-MTV100 (Bio Medical Science, Tokyo, Japan), followed by centrifugation at 18,000×g for 15 min at 4 °C. The clear supernatant was collected and diluted with RO water so that the measured value was within the range of the lactate measurement.
Amino acid analysis
Amino acids (except tryptophan) were measured following the AOAC 994.12 method [26], by using an ion-exchange chromatography system (Hitachi LA8080, Tokyo, Japan) equipped with postcolumn ninhydrin derivatization (Na type-cation exchange resin) on the basis of a ninhydrin reaction at 135 C. Absorbance was detected at 570 nm or 440 nm (for the proline). Tryptophan was determined as described previously [27]. In brief, tryptophan was quantified using an HPLC system (HP 1260; Agilent) equipped with an AdvanceBio AAA column (Agilent). The sample was eluted with a gradient NaH2PO4:(MeOH + CAN + H2O) and detected using a fluorescence detector (FLD: ex = 340 nm, em = 450 nm). γ-Aminobutyric acid (GABA) was pretreated and analyzed as described previously [28]. In brief, GABA was quantified using an HPLC system (Agilent 1100; Agilent) equipped with a Supelcosil LC-DABS column (Merck Millipore). The sample was eluted with a gradient of 0.025 M CH3COONa (pH 6.8)-MeOH (70:30 (v/v)) and detected with a diode array detector.
Vitamin B analysis
For vitamin B analysis, pretreatment and determination procedures were performed as described previously [29]. Detection was performed using a liquid chromatography-mass selective detector (LC-MSD) (Agilent 1100; Agilent) equipped with a reverse-phase C18 column (Agilent). The sample was eluted with 5 mM heptafluorobutyric acid-methanol.
Total phenolic compound analysis
Total phenolic content (TPC) was determined using the Folin-Ciocalteu reaction per Xiong et al. [30]. A solution consisting of 20 µL of extracted sample solution, 100 µL of Folin-Ciocalteu reagent and 50 µL of distilled water was transferred into a 96-well flat-bottom microplate, mixed thoroughly and incubated in the dark at ambient temperature for 8 min. An 80 µL of 7.5% (w/v) Na2CO3 was added and incubated at 40 C for 30 min. Absorbance was measured at 765 nm using a microplate reader (Infinite M200; TECAN, Männedorf, Switzerland). TPC is expressed as gallic acid equivalent per gram (mg GAE/g).
Bioactivity assay
Antioxidant activity was estimated by a DPPH radical–scavenging assay per previous reports [31,32]. Absorbance was measured using a microplate reader (Infinite M200; TECAN) at 517 nm against a 95% (v/v) ethanol blank. The percentage of DPPH discoloration of the samples was calculated using Eq. (2), where A sample denotes the absorbance of the test sample and A control denotes the absorbance of the negative control taken after adding the DPPH solution to the extraction solvent. The free radical-scavenging activity of FSPO-PJ1 amazake and RB-AMA is expressed as micromoles of Trolox equivalent per gram of sample (µmol TE/g) based on a Trolox calibration curve.

The anti-inflammatory properties of FSPO-PJ1 amazake and RB-AMA were assessed based on the inhibition of nitric oxide (NO) production in lipopolysaccharide (LPS)-stimulated RAW 264.7 cells using the pretreatment method. RAW 264.7 cells (1×105 cells/well) seeded into 96-well plates were pretreated with either 10 mg/mL FSPO-PJ1 amazake or 10 mg/mL RB-AMA samples for 1 h. The cells were then stimulated with 1 μg/mL of LPS from Escherichia coli 0111:B4 (Sigma-Aldrich, St. Louis, MO, USA) and incubated for an additional 24 h. Experimental controls were the following: Cells treated with 1 μg/mL LPS only (positive control), the cells treated with a cell culture medium (DMEM) only (untreated sample) and cells pretreated with 100 mM NG-nitro-l-arginine methyl ester (L-NAME), an iNOS inhibitor (Sigma-Aldrich) (standard inhibition control). NO production in the cell culture supernatants was determined using the Griess reaction method [33]. Absorbance was measured at 540 nm using a microplate reader (Infinite M200 PRO; TECAN). NO inhibition was calculated using Eq. (3), where A denotes the absorbance of the positive control (LPS only), B denotes the absorbance of the sample (sample + LPS) and C denotes the absorbance of the untreated sample (cell culture medium only).
![]()
Cytotoxicity assay
The cytotoxicity of the anti-inflammatory treatment conditions was evaluated using the 3-(4,5-dimethylthiazol-2-yl)-2,5-diphenyltetrazolium bromide (MTT) assay [34]. The suspensions of the aforementioned treated RAW 264.7 cells were added into 96-well plates and incubated for 24 h at 37 C under 5% CO2. After incubation, the cell culture medium was removed and maintained with 0.5 mg/mL MTT solution for 3 - 4 h. The formazan crystals that formed were dissolved in dimethyl sulfoxide. Cell viability was determined by measuring the absorbance at 570 nm and calculated according to Eq. (4), where A sample denotes the absorbance of the sample (sample + LPS) and A control denotes the absorbance of the untreated sample (cell culture medium only):

Statistical analysis
FSPO-PJ1 amazake and RB-AMA sampled three replicates. Statistical analyses of the mean values of metabolite concentration and bioactivity of FSPO-PJ1 amazake and RB-AMA were conducted using SPSS v25 (IBM, Armonk, NY, USA). The assumptions of the experiments were independence of data, normal distribution and homogeneity of variance. The significance of differences in each metabolite between FSPO-PJ1 amazake and RB-AMA was determined using a paired t test. Significant differences in the NO inhibition and cytotoxicity of each treatment were determined using one-way analysis of variance. p-value < 0.05 was set as statistically significant.
Results and discussion
Isolation and screening of LAB strain
We collected 46 Thai fermented food samples from the central, eastern, northeastern and western regions of Thailand, yielding 244 strains of LAB. All strains were Gram-positive rods or cocci and catalase negative. Primary screening for thermotolerance revealed 4 LAB strains that grew on MRS agar at 45 and 50 C: FV-KS45C2, FV-KS45C12, FSPO-KK26 and FSPO-PJ1 (Figure 2). However, no LAB grew on MRS agar at 55 C (Figure 2). The 50–55 C temperature range is optimum for the amylase activity of A. oryzae in rice koji and possibly reduces the risk of foodborne pathogen contamination [10,35,36]. Therefore, a secondary screening was evaluated in riceberry rice amazake by using the parallel fermentation method at 45, 50 and 55 C.
Figure 2 Primary thermotolerance screening of LAB isolates on MRS agar plates. The plates were incubated at (A) 45, (B) 50 and (C) 55 °C for 24 h.
As demonstrated in Table 1, FSPO-PJ1 was the only strain that yielded a LAB–amazake culture pH of < 4 at the maximum temperature of 50 C. This pH was significantly lower than those of the other LAB strains and the mock-inoculated samples (Table 1). It is thought that the monosaccharides and oligosaccharides produced by the saccharification of rice starch by enzymes derived from rice koji were used as substrates for lactic acid fermentation of the FSPO-PJ1 strain. Moreover, none of the LAB strain used for secondary screening at 55 C could acidify the LAB–amazake culture, with pH being similar to that of the mock-inoculated sample (Table 1). An acidic pH (< 4) in LAB-fermented amazake is preferred because it can inhibit foodborne pathogens [3,4]. Moreover, the high temperature at 50 C possibly limits the growth of foodborne pathogens, including B. cereus and S. aureus [35,36]. Consequently, FSPO-PJ1 was selected for further study. In addition, sugar content from rice saccharification at each temperature was similar among the LAB–amazake culture and the mock-inoculated sample (Table 1), indicating that LAB inoculation did not interfere with saccharification activity in amazake.
Table 1 pH and sugar content of LAB–amazake culture fermented with LAB strain.
Strain |
Temperature |
|||||
45 °C |
50 C |
55 C |
||||
pH† |
Sugar content§ ( Brix) |
pH† |
Sugar content§ ( Brix) |
pH‡ |
Sugar content§ ( Brix) |
|
FV-KS45C2 |
3.78 0.07a |
37.50 0.04 |
5.61 0.07d |
37.50 0.04 |
5.70 0.02 |
37.50 0.02 |
FV-KS45C12 |
3.83 0.06a |
37.52 0.02 |
5.43 0.04e |
37.52 0.02 |
5.71 0.03 |
37.54 0.01 |
FSPO-KK26 |
3.68 0.04b |
37.51 0.02 |
5.58 0.05d |
37.51 0.02 |
5.71 0.03 |
37.52 0.02 |
FSPO-PJ1 |
3.69 0.03b |
37.51 0.03 |
3.85 0.03f |
37.51 0.03 |
5.70 0.03 |
37.51 0.02 |
Mock-inoculated |
5.70 0.02c |
37.51 0.02 |
5.68 0.02g |
37.51 0.02 |
5.71 0.01 |
|
†The pH of LAB-amazake culture fermented with LAB strain and mock-inoculated for 45 and 50 C were significant different (p-value 0.05), except those indicated with same letter, which were not significant different.
‡The pH of LAB-amazake culture fermented with LAB strain and mock-inoculated for 55 C were not significant different (p-value 0.05).
§The sugar contents of LA-amazake culture fermented with LAB strain and mock-inoculated for each temperature were not significant different (p-value 0.05).
Antagonism against foodborne pathogens
B. cereus is usually found in the environment and cereals, especially rice, whereas S. aureus resides on human skin. Both of them can tolerate high temperatures up to 45 C [35,36]. Although the amazake lactic producing temperature (50 C) and low pH (< 4.0) can reduce contamination risk, we determined the antagonistic activity of FSPO-PJ1-fermented amazake against B. cereus TISTR 687 and S. aureus DMST 8840.
FSPO-PJ1 inhibited both B. cereus TISTR 687 and S. aureus DMST 8840 (Figure 3), with a ZDI of 32.17 0.76 (strong inhibition) and 16.67 0.29 mm (intermediate inhibition), respectively. The R values were 13.92 0.29 and 6.17 0.14, respectively, indicating high inhibition capacity. P. acidilactici is a bacteriocin-producing LAB that inhibits foodborne pathogens, such as Listeria monocytogenes, Salmonella Typhimurium, Escherichia coli O157:H7, B. cereus, and S. aureus [37,38]. Notably, P. acidilactici PFC69 has been proposed for use in cereal-based fermented foods due to its inhibitory effects on B. cereus and S. aureus [38].
Figure 3 Foodborne pathogen antagonist of LAB strain FSPO-PJ1 against (A) B. cereus TISTR 687 and (B) S. aureus DMST 8840 by agar overlay technique. The clear zones of inhibition observed around the FSPO-PJ1 colonies correspond to the suppression of pathogen growth.
Bacterial identification and phylogenetic analysis
Morphologically, FSPO-PJ1 is a Gram-positive coccus in pairs and tetrads. Its whole-genome sequencing yielded 1,108 contigs, comprising a genome of approximately 2.40 Mb, with a GC content of 41.8%. Using BLASTN for local sequence alignment, FSPO-PJ1 was identified as Pediococcus acidilactici (98.82% ANI and 99.39% AAI). A pan-genome-based phylogenetic tree was constructed based on the presence and absence of core and accessory genes of P. acidilactici FSPO-PJ1 and other Pediococcus strains. Lactiplantibacillus plantarum SRCM100442 was used as the outgroup. The rooted phylogenetic tree (Figure 4) confirmed that P. acidilactici FSPO-PJ1 belonged to P. acidilactici.

Figure 4 Phylogenetic tree of P. acidilactici FSPO-PJ1 and other Pediococcus strains. The outgroup was L. plantarum SRCM100442. P. acidilactici FSPO-PJ1, newly isolated in this study, is indicated by an asterisk (*). The scale represents a 0.1% difference in the average BLASTN score.
Metabolites of riceberry rice amazake lactic
Riceberry rice amazake lactic fermented with P. acidilactici FSPO-PJ1 was prepared using the parallel fermentation method at 50 C for 16 h (Figure 1). The pH of FSPO-PJ1 amazake and RB-AMA was 3.76 0.10 and 5.71 0.17, respectively and their sugar content was similar (37.46 0.06 vs. 37.40 0.53 Brix). We compared their metabolites and bioactivity to verify the enhanced nutritional and bioactive properties of FSPO-PJ1-fermented riceberry rice amazake lactic (Table 2). Saccharification of rice by -amylase and glucoamylase from A. oryzae in rice koji has been found to provide mono-, di- and oligosaccharides to amazake [11]. FSPO-PJ1 amazake and RB-AMA had similar concentrations of glucose, the major sugar in amazake products. However, the maltose concentration in FSPO-PJ1 amazake was approximately 50% of that in RB-AMA (Table 2). Moreover, maltotriose was not detected in FSPO-PJ1 amazake (Table 2), whereas the concentrations of the isomaltooligosaccharides (IMOs) - isomaltose and isomaltotriose - were significantly higher in FSPO-PJ1 amazake than in RB-AMA (Table 2). These IMOs are prebiotic and commonly used as sweeteners in food products, which are produced by the conversion of starch to soluble branched molecules by hydrolases and glucanotransferase enzymes, including those from A. oryzae [39]. The lower maltose content in the lactic acid fermented product might be due to digestion and/or assimilation by P. acidilactici. However, this did not affect the isomaltose content, which may contribute to the product’s prebiotic properties. Furthermore, the reduction in pH during fermentation appeared to have no significant impact on isomaltose production. These results demonstrate the suitability of the strain FSPO-PJ1 for lactic acid fermentation of amazake without reducing functional oligosaccharides. Moreover, lactic acid, a metabolite of LAB fermentation, was detected only in FSPO-PJ1 amazake (Table 2). Lactic acid not only inhibits foodborne pathogens but also improves health function by reducing proinflammatory cytokine secretion in macrophages and dendritic cells and lowering reactive oxygen species burden in intestinal enterocytes [40].
The amino acids in amazake are the result of rice protein degradation caused by A. oryzae protease and deoxypeptidase in rice koji [11]. In the present study, compared with RB-AMA, FSPO-PJ1 amazake had increased levels of eight amino acids: Histidine, lysine, cysteine, glycine, proline, alanine, leucine and methionine (Table 2). However, the concentrations of aspartic acid, valine, tyrosine and GABA were comparable in both (Table 2). Our results align with those of a previous study in which L. sakei UONUMA was found to enhance the amino acid content of glutamic acid, glycine and proline in amazake lactic [11]. Toe et al. [6] demonstrated that eight strains of P. pentosaceus, P. acidilactici, and L. plantarum isolated from tapai ubi, a Malaysian fermented food made from cassava, produced different amounts and species of amino acid because these LAB contained different extracellular proteolytic enzymes. Because amino acids are important nutrients for the growth, reproduction and maintenance of organisms [6], using amino acid–producing LAB can enhance the nutritional value of fermented food.
Amazake is a known source of vitamin B. We found that, compared with RB-AMA, using P. acidilactici FSPO-PJ1 as a starter culture significantly improved vitamin B content in riceberry rice amazake lactic. FSPO-PJ1 amazake contained significantly higher amounts of thiamine (B1), riboflavin (B2), nicotinamide (B3), folic acid (B9) and vitamin B complex (Table 2). Vitamin B is essential for various cellular functions, including energy metabolism, immune system activation, cellular signaling and maintenance processes in cells and tissues and cell membrane dynamics. Using vitamin B–producing LAB strains can thus further improve the health benefits of fermented foods, making them an attractive food choice. Previously, L. sakei UONUMA was reported as a potential LAB that improved concentration of vitamins B2, B3 and B6 in amazake lactic [11]. Similarly, some Pediococcus, including P. acidilactici WNYM01, P. acidilactici WNYM02 and P. acidilactici WNYM03, can produce vitamins B2 and B6 and P. acidilactici NCDC 252 can produce vitamin B12 [7,8].
Table 2 Metabolites of FSPO-PJ1 amazake and RB-AMA.
Metabolites |
FSPO-PJ1 amazake |
RB-AMA |
|
Sugar (g/100g) |
Glucose |
17.57 0.34a |
17.93 0.49a |
|
Maltose |
0.87 0.11 |
1.85 0.10 |
|
Isomaltose |
1.86 0.04 |
1.67 0.08 |
|
Maltotriose |
ND |
0.052 0.002 |
|
Isomaltotriose |
0.009 0.000 |
0.003 0.000 |
Lactic acid (mg/100g) |
|
926.67 78.21 |
ND |
Amino acid (mg/100g) |
Arginine |
201.93 0.20 |
238.71 0.35 |
|
Histidine |
89.77 0.50 |
86.41 0.13 |
|
Lysine |
125.88 0.31 |
118.67 0.33 |
|
Aspartic acid |
315.11 1.45b |
320.95 3.68b |
|
Glutamic acid |
632.72 1.43 |
637.39 2.13 |
|
Serine |
179.09 0.98 |
186.05 0.49 |
|
Threonine |
133.11 0.50 |
135.95 0.11 |
|
Cysteine |
47.91 0.22 |
45.76 0.06 |
|
Glycine |
165.74 0.29 |
163.69 0.22 |
|
Proline |
137.05 0.36 |
128.93 0.39 |
|
Alanine |
221.97 0.07 |
204.88 0.47 |
|
Valine |
190.15 0.13c |
189.64 0.62c |
|
Isoleucine |
131.75 0.22 |
132.91 0.11 |
|
Leucine |
273.79 1.22 |
265.64 0.14 |
|
Methionine |
92.72 0.34 |
86.76 0.32 |
|
Phenylalanine |
161.76 0.23 |
178.98 0.29 |
|
Tyrosine |
84.63 0.48d |
83.96 0.18d |
|
Tryptophan |
11.46 0.10 |
15.51 0.23 |
|
GABA |
2.74 0.06e |
2.73 0.04e |
Vitamin B (µg/100g) |
B1 |
346.25 1.04 |
163.26 0.25 |
|
B2 |
213.39 0.24 |
139.73 0.36 |
|
B3 |
177.25 0.77 |
129.33 0.01 |
|
B5 |
199.66 0.30 |
354.54 0.26 |
|
B6 |
11.59 0.32 |
28.23 0.11 |
|
B9 |
21.40 0.26 |
14.11 0.11 |
|
B12 |
ND |
ND |
|
B Complex |
969.55 1.03 |
829.20 0.61 |
Comparisons were made between FSPO-PJ1 amazake and RB-AMA for each metabolite only. Each metabolite of FSPO-PJ1 amazake and RB-AMA was significantly different (p-value 0.05), except those indicated with the same letter.
Bioactive substance and bioactivity of riceberry rice amazake lactic
Phenolic compounds are bioactive substances that exhibit health benefit functions, such as antioxidant, anti-inflammatory and anticancer activities [41]. In this study, FSPO-PJ1 amazake contained a significantly higher TPC than RB-AMA (1.274 0.001 vs. 1.080 0.001 mg GAE/g). Furthermore, a DPPH radical-scavenging assay revealed that FSPO-PJ1 amazake had 5.3-fold greater antioxidant activity than RB-AMA (0.278 0.003 vs. 0.052 0.002 mg TE/g). Although the antioxidant activity of traditional amazake was reported on previously [42], our study clarified that fermentation with P. acidilactici FSPO-PJ1 was able to enhance the antioxidant activity of amazake. Using Pediococcus to produce fermented food improves both phenolic compounds and antioxidant activity. For example, avocado leaf extract fermented with P. pentosaceus CECT 4695T, L. brevis CECT 5354, P. acidilactici CECT 5765T and L. plantarum CECT 9567 had an increase in phenolic compounds and antioxidant activities [43]. Similarly, P. acidilactici F3 was able to enhance phenolic compounds and antioxidant activity in fermented soymilk [4].
LPS, a component of the outer membrane of Gram-negative bacteria, activates this inflammatory response and stimulates the production of NO, a potent proinflammatory mediator that can damage immune cells and surrounding tissues. Inhibition of NO synthesis is expected to reduce the risk of some chronic diseases, such as cancer, diabetes and cardiovascular diseases [33]. We evaluated the anti-inflammatory activity of FSPO-PJ1 amazake by assessing its inhibitory effect on LPS-stimulated NO. The amount of amazake sample at 10 mg/mL was the appropriate concentration without cytotoxicity (data not shown). A 100 µM of L-NAME was used as a standard inhibition control. As illustrated in Figure 5(A), FSPO-PJ1 amazake reduced NO by 46.07% 0.70%, which is significantly greater than that achieved by L-NAME (40.92% 0.50%) or RB-AMA (40.86% 1.80%). LPS alone caused negligible NO inhibition (approximately 0%), whereas the untreated sample (cell culture medium only) served as the baseline for no inflammation (approximately 100% inhibition) (Figure 5(A)). These results demonstrate that FSPO-PJ1 amazake has a superior anti-inflammatory effect than RB-AMA or L-NAME. The cytotoxicity assay revealed that the viability of RAW 264.7 macrophages exceeded 80% across all treatment conditions (Figure 5(B)), indicating that the inhibition of NO formation was not due to cytotoxicity but rather to treatment with the amazake samples.
There are previous reports that elucidate anti-inflammatory mechanisms of LAB as follows. Shakya et al. [44] described the phenolic compound generated by the fermentation of medicinal herbal extract with Lactobacillus brevis 174A as producing anti-inflammation activity by inhibiting NO synthesis in LPS-stimulated RAW 264.7 cells, suppressing inflammatory cytokines IL-6 and TNF-α and downregulating iNOS, IL-6, TNF-α and IL-1β gene expressions. Similarly, Woo et al. [45] reported that exopolysaccharides from a probiotic LAB P. acidilactici strain exerted anti-inflammatory effects by inhibiting the TLR4/MyD88/NF-κB, MAPK and AP-1 signaling pathways in RAW 264.7 cells.

Figure 5 Anti-inflammatory activity of riceberry rice amazake lactic fermented with P. acidilactici FSPO-PJ1 in LPS-stimulated RAW 264.7 cells. (A) NO inhibition in RAW 264.7 cells using the pretreatment method. Cells were pretreated with 100 mM L-NAME, 10 mg/mL FSPO-PJ1 amazake, or 10 mg/mL RB-AMA and inflammation was induced with 1 µg/mL LPS. (B) The viability of RAW 264.7 cells in each anti-inflammatory treatment condition was assessed using the MTT method. All experiments were performed in triplicate. Error bars represent standard deviations from the mean. Bars with different letters indicate significant differences (p-value < 0.05).
Conclusions
P. acidilactici FSPO-PJ1 is a newly isolated thermotolerant from Thai fermented spring onion. Fermentation using P. acidilactici FSPO-PJ1 can enhance the nutritional including lactic acid, amino acid (histidine, lysine, cysteine, glycine, proline, alanine, leucine and methionine), vitamin B (B1, B2, B3 and B9) and bioactive properties (antioxidant and anti-inflammatory activities) of riceberry rice amazake lactic. The strain also inhibited B. cereus and S. aureus, indicating its food-safety profile. FSPO-PJ1 is thus a promising candidate for developing novel functional fermented foods. Future studies should comprehensively investigate whole-genome sequencing and gene functional annotation to elucidate its other health benefits.
Acknowledgments
This work was financially supported by the Kasetsart University Research and Development Institute (grant number: FF(KU)19.67) and also partially by the JIRCAS research program “Indigenous crops and food design”. Rice koji was kindly supported by Kojiya Sanzaemon. We thank Sudeep Agarwal (www.scribendi.com) for editing a draft of this manuscript.
Declaration of generative AI in scientific writing
Gemini 2.5 Flash was exclusively used for the purpose of improving the language clarity of this work. The AI tool was used only after the core scientific content, data, and conclusions were finalized by the authors. After using this tool, we carefully reviewed and edited the content as necessary and take full responsibility for the final content of the published article.
CRediT author statement
Sirinan Shompoosang: Conceptualization, Methodology, Formal analysis, Investigation, Resources, Data Curation, Writing - Original Draft, Writing - Review & Editing, Visualization, Project administration. Junichiro Marui: Methodology, Formal analysis, Investigation, Resources, Writing - Original Draft, Writing - Review & Editing. Safiah Saah: Methodology, Formal analysis, Investigation, Writing - Original Draft, Writing - Review & Editing. Thoranin Intarajak: Methodology, Formal analysis, Data Curation, Writing - Original Draft, Writing - Review & Editing, Visualization. Patthinan Varichanan: Methodology, Writing - Original Draft, Writing - Review & Editing.
References
[1] BNA Hakim, NJ Xuan and SNH Oslan. A comprehensive review of bioactive compounds from lactic acid bacteria: Potential functions as functional food in dietetics and the food industry. Foods 2023; 12(15), 2850.
[2] HM Al‑Emran, JF Moon, ML Miah, NS Meghla, RC Reuben, MJ Uddin, H Ibnat, SL Sarkar, PC Roy, MS Rahman, ASMRU Alam, OK Islam and IK Jahid. Genomic analysis and in vivo efficacy of Pediococcus acidilactici as a potential probiotic to prevent hyperglycemia, hypercholesterolemia and gastrointestinal infections. Scientific Reports 2022; 12(1), 20429.
[3] Y Shim, JY Lee and J Jung. Effects of kimchi-derived lactic acid bacteria on reducing biological hazards in kimchi. Journal of Microbiology and Biotechnology 2024; 34(12), 2586-2595.
[4] S Chan, K Jantama, C Prasitpuriprecha, S Wansutha, C Phosriran, L Yuenyaow, KC Cheng and SS Jantama. Harnessing fermented soymilk production by a newly isolated Pediococcus acidilactici F3 to enhance antioxidant level with high antimicrobial activity against food-borne pathogens during co-culture. Foods 2024; 13(13), 2150.
[5] M Raccach. Pediococcus. In: CA Batt and ML Tortorello (Eds.). Encyclopedia of food microbiology. 2nd ed. Academic Press, California, United States, 2014.
[6] CJ Toe, HL Foo, TC Loh, R Mohamad, RA Rahim and Z Idrus. Extracellular proteolytic activity and amino acid production by lactic acid bacteria isolated from Malaysian foods. International Journal of Molecular Sciences 2019; 20(7), 1777.
[7] NM Mansour, WS Elkalla, YM Ragab and MA Ramadan. Inhibition of acetic acid-induced colitis in rats by new Pediococcus acidilactici strains, vitamin producers recovered from human gut microbiota. PLoS One 2021; 16(7), e0255092.
[8] P Bansal, R Kumar and S Dhanda. Characterization of starter cultures and nutritional properties of Pediococcus acidilactici NCDC 252: A potential probiotic of dairy origin. Journal of Food Processing and Preservation 2022; 46(10), e16817.
[9] H Hamajima, M Tanaka, M Miyagawa, M Sakamoto, T Nakamura, T Yanagita, M Nishimukai, S Mitsutake, J Nakayama, K Nagao and H Kitagaki. Koji glycosylceramide commonly contained in Japanese traditional fermented foods alters cholesterol metabolism in obese mice. Bioscience, Biotechnology and Biochemistry 2019; 83(8), 1514-1522.
[10] A Kurahashi. Ingredients, functionality and safety of the Japanese traditional sweet drink amazake. Journal of Fungi 2021; 7(6), 469.
[11] Y Oguro, T Nishiwaki, R Shinada, K Kobayashi and A Kurahashi. Metabolite profile of koji amazake and its lactic acid fermentation product by Lactobacillus sakei UONUMA. Journal of Bioscience and Bioengineering 2017; 124(2), 178-183.
[12] M Sakurai, M Kubota, A Iguchi, T Shigematsu, T Yamaguchi, S Nakagawa, A Kurahashi, Y Oguro, T Nishiwaki, K Aihara and S Sato. Effects of koji amazake and its lactic acid fermentation product by Lactobacillus sakei UONUMA on defecation status in healthy volunteers with relatively low stool frequency. Food Science and Technology Research 2019; 25(6), 853-861.
[13] T Enomoto, A Kojima-Nakamura, K Kodaira, Y Oguro and A Kurahashi. Koji amazake maintains water content in the left cheek skin of healthy adults: A randomized, double-blind, placebo-controlled, parallel-group, comparative trial. Clinical, Cosmetic and Investigational Dermatology 2022; 15, 1283-1291.
[14] R Mungkung, S Dangsiri and SH Gheewala. Development of a low-carbon, healthy and innovative value-added riceberry rice product through life cycle design. Clean Technologies and Environmental Policy 2021; 23, 2037-2047.
[15] P Pothinuch, K Jongrattanavit, K Leelajaruwan and N Prichapan. Effects of anaerobic germination and enzymatic saccharification on chemical compositions of functional drink from riceberry rice. Journal of Current Science and Technology 2024; 14(1), 2.
[16] T Anuyahong, C Chusak and S Adisakwattana. Incorporation of anthocyanin-rich riceberry rice in yogurts: Effect on physicochemical properties, antioxidant activity and in vitro gastrointestinal digestion. LWT 2020; 129, 109571.
[17] D Halder, M Mandal, SS Chatterjee, NK Pal and S Mandal. Indigenous probiotic Lactobacillus isolates presenting antibiotic like activity against human pathogenic bacteria. Biomedicines 2017; 5(2), 31.
[18] Babraham Bioinformatics, Available at: https://www.bioinformatics.babraham.ac.uk/projects/fastqc/, accessed January 2025.
[19] S Chen, Y Zhou, Y Chen and J Gu. Fastp: An ultra-fast all-in-one FASTQ preprocessor. Bioinformatics 2018; 34(17), i884-i890.
[20] AM Bolger, M Lohse and B Usadel. Trimmomatic: A flexible trimmer for Illumina sequence data. Bioinformatics 2014; 30(15), 2114-2120.
[21] A Prjibelski, D Antipov, D Meleshko, A Lapidus and A Korobeynikov. Using SPAdes de novo assembler. Current Protocols in Bioinformatics 2020; 70(1), e102.
[22] A Priyam, BJ Woodcroft, V Rai, I Moghul, A Munagala, F Ter, H Chowdhary, I Pieniak, LJ Maynard, MA Gibbins, H Moon, A Davis-Richardson, M Uludag, NS Watson-Haigh, R Challis, H Nakamura, E Favreau, EA Gómez, T Pluskal, G Leonard, W Rumpf and Y Wurm. Sequenceserver: A modern graphical user interface for custom BLAST databases. Molecular Biology and Evolution 2019; 36(12), 2922-2924.
[23] T Seemann. Prokka: Rapid prokaryotic genome annotation. Bioinformatics 2014; 30(14), 2068-2069.
[24] AJ Page, CA Cummins, M Hunt, VK Wong, S Reuter, MTG Holden, M Fookes, D Falush, JA Keane and J Parkhill. Roary: Rapid large-scale prokaryote pan genome analysis. Bioinformatics 2015; 31(22), 3691-3693.
[25] I Letunic and P Bork. Interactive Tree of Life (iTOL) v6: Recent updates to the phylogenetic tree display and annotation tool. Nucleic Acids Research 2024; 52(W1), W78-W82.
[26] AOAC International. Official method 994.12 amino acids in feeds: Performic acid oxidation with acid hydrolysis-sodium metabisulfite method. In: GW Latimer (Ed.). Official methods of analysis of AOAC International. AOAC International, Rockville, United States, 2023.
[27] Z Dai, Z Wu, S Jia and G Wu. Analysis of amino acid composition in proteins of animal tissues and foods as pre-column o-phthaldialdehyde derivatives by HPLC with fluorescence detection. Journal of Chromatography B 2014; 964, 116-127.
[28] P Prakongsil, S Sajjabut, W Pewlong, R Picha and N Thamrongsiripak. Enhancing gamma aminobutyric acid (GABA) content in germinated Thai Hom Mali brown rice by low dose electron beam irradiation. Science & Technology Asia 2023; 28(3), 210-219.
[29] H Zia, N Fischbach, M Hofsommer and A Slatnar. Development and validation of HPLC-MS/MS method for simultaneous analysis of B vitamins present naturally or after fortification in fruit juices. LWT 2023; 184, 115103.
[30] L Xiong, J Yang, Y Jiang, B Lu, Y Hu, F Zhou, S Mao and C Shen. Phenolic compounds and antioxidant capacities of 10 common edible flowers from China. Journal of Food Science 2014; 79(4), C517-C525.
[31] X Ge, L Jing, K Zhao, C Su, B Zhang, Q Zhang, L Han, X Yu and W Li. The phenolic compounds profile, quantitative analysis and antioxidant activity of four naked barley grains with different color. Food Chemistry 2021; 335, 127655.
[32] YL Zhu, HS Zhang, XS Zhao, HH Xue, J Xue and YH Sun. Composition, distribution and antioxidant activity of phenolic compounds in 18 soybean cultivars. Journal of AOAC International 2018; 101(2), 520-528.
[33] T Joo, K Sowndhararajan, S Hong, J Lee, SY Park, S Kim and JW Jhoo. Inhibition of nitric oxide production in LPS-stimulated RAW 264.7 cells by stem bark of Ulmus pumila L. Saudi Journal of Biological Sciences 2014; 21(5), 427-435.
[34] G Yang, K Lee, M Lee, I Ham and HY Choi. Inhibition of lipopolysaccharide-induced nitric oxide and prostaglandin E2 production by chloroform fraction of Cudrania tricuspidata in RAW 264.7 macrophages. BMC Complementary and Alternative Medicine 2012; 12, 250.
[35] E Hurtado-Bautista, LF Pérez Sánchez, A Islas-Robles, G Santoyo and G Olmedo-Alvarez. Phenotypic plasticity and evolution of thermal tolerance in bacteria from temperate and hot spring environments. PeerJ 2021; 9, e11734.
[36] DM Missiakas and O Schneewind. Growth and laboratory maintenance of Staphylococcus aureus. Current Protocols in Microbiology 2013. https://doi.org/10.1002/9780471729259.mc09c01s28
[37] GK İncili, M Akgöl, P Karatepe, H Kanmaz, B Kaya, A Tekin and AA Hayaloğlu. Inhibitory effect of bioactive compounds derived from freeze-dried paraprobiotic of Pediococcus acidilactici against food-borne pathogens: In-vitro and food model studies. Food Research International 2023; 170, 113045.
[38] Hİ Kaya and Ö Şimşek. Characterization of Pediococcus acidilactici PFC69 and Lactococcus lactis PFC77 bacteriocins and their antimicrobial activities in tarhana fermentation. Microorganisms 2020; 8(7), 1083.
[39] W Sorndech. Isomaltooligosaccharides as prebiotics and their health benefits. In: PS Panesar and AK Anal (Eds.). Probiotics, prebiotics and synbiotics: Technological advancements towards safety and industrial applications. John Wiley & Sons, New Jersey, United States, 2022, p. 361-377.
[40] S Fitsum, G Gebreyohannes and DB Sbhatu. Bioactive compounds in fermented foods: Health benefits, safety and future perspectives. Applied Food Research 2025; 5(2), 101097.
[41] MM Rahman, MS Rahaman, MR Islam, F Rahman, FM Mithi, T Alqahtani, MA Almikhlafi, SQ Alghamdi, AS Alruwaili, MS Hossain, M Ahmed, R Das, TB Emran and MS Uddin. Role of phenolic compounds in human disease: Current knowledge and future prospects. Molecules 2021; 27(1), 233.
[42] S Matsugo, T Sakamoto and N Wada. Liposoluble anti-oxidative components in Japanese traditional fermented food “Amazake” made from brown rice. Journal of Bioprocessing and Biotechniques 2018; 8(1), 1000317.
[43] SD Montijo-Prieto, MDC Razola-Díaz, F Barbieri, G Tabanelli, F Gardini, M Jiménez-Valera, A Ruiz-Bravo, V Verardo and AM Gómez-Caravaca. Impact of lactic acid bacteria fermentation on phenolic compounds and antioxidant activity of avocado leaf extracts. Antioxidants 2023; 12(2), 298.
[44] S Shakya, N Danshiitsoodol, S Sugimoto, M Noda and M Sugiyama. Anti-oxidant and anti-inflammatory substance generated newly in Paeoniae Radix Alba extract fermented with plant-derived Lactobacillus brevis 174A. Antioxidants 2021; 10(7), 1071.
[45] IK Woo, JH Hyun, HJ Jang, NK Lee and HD Paik. Probiotic Pediococcus acidilactici strains exert anti-inflammatory effects by regulating intracellular signaling pathways in LPS-induced RAW 264.7 cells. Probiotics and Antimicrobial Proteins 2024; 17, 3258-3269.
